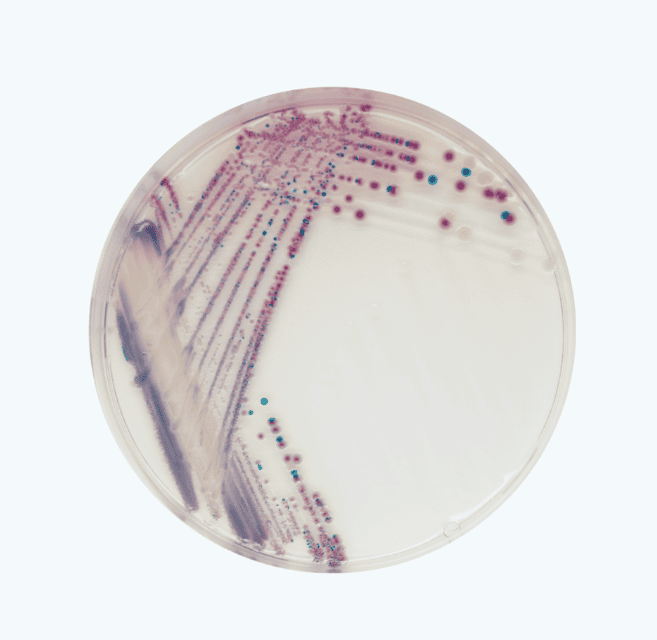
Colonias de Vibrio

Agar cromogénico Chromagar Vibrio para Mazatlán Sinaloa
Precios:
$ 6,029 MXN*
-
Disponibilidad de Agar cromogénico Chromagar Vibrio para Mazatlán Sinaloa:En stock
-
Mínimo de venta de Agar cromogénico Chromagar Vibrio para Mazatlán Sinaloa:1 frasco
-
Unidad de Agar cromogénico Chromagar Vibrio para Mazatlán Sinaloa:Frascos
-
Tiempo de entrega de Agar cromogénico Chromagar Vibrio para Mazatlán Sinaloa:Inmediato Salvo Venta
Descripción de Agar cromogénico Chromagar Vibrio para Mazatlán Sinaloa:
Chromagar Vibrio de 5 Litros,listo para usar, Es el producto más usado en el mundo para cualquier empresa del giro acuícola.
Chromagar Vibrio de 5 Litros,listo para usar, Es el producto más usado en el mundo para cualquier empresa del giro acuícola.
* Los rangos de precio son orientativos, el costo final depende de diferentes factores, solicita una cotización personalizada para tus necesidades.


-
Cobertura de Agar cromogénico Chromagar Vibrio para Mazatlán Sinaloa Regional
Sinaloa -
De Agar cromogénico Chromagar Vibrio para Mazatlán Sinaloa somos Distribuidor
4.2
Gabriela Ramirez Jimenez
4 años atrás
robert chavolla
8 años atrás
ale kim
8 años atrás
GABRIEL MENDOZA
7 años atrás
¡Atención! Las opiniones expuestas se toman de las que los usuarios escribieron en el registro de Google de esta empresa. No son directamente de nuestra plataforma en Cosmos. Te sugerimos validar tú mismo esta información.


-
Cobertura de Agar cromogénico Chromagar Vibrio para Mazatlán Sinaloa Regional
Sinaloa -
De Agar cromogénico Chromagar Vibrio para Mazatlán Sinaloa somos Distribuidor
4.2
Gabriela Ramirez Jimenez
4 años atrás
robert chavolla
8 años atrás
ale kim
8 años atrás
GABRIEL MENDOZA
7 años atrás
¡Atención! Las opiniones expuestas se toman de las que los usuarios escribieron en el registro de Google de esta empresa. No son directamente de nuestra plataforma en Cosmos. Te sugerimos validar tú mismo esta información.
Otros productos que vende Serco Comercial

$ 22,700 MXN
Min. Caja con 100




$ 22,700 MXN
Min. Caja con 100



¿Necesitas una cotización personalizada?
Nuestro equipo técnico puede ayudarte a seleccionar Agar cromogénico Chromagar Vibrio para Mazatlán Sinaloa ideal según tu línea de producción, velocidad y tipo de material.









